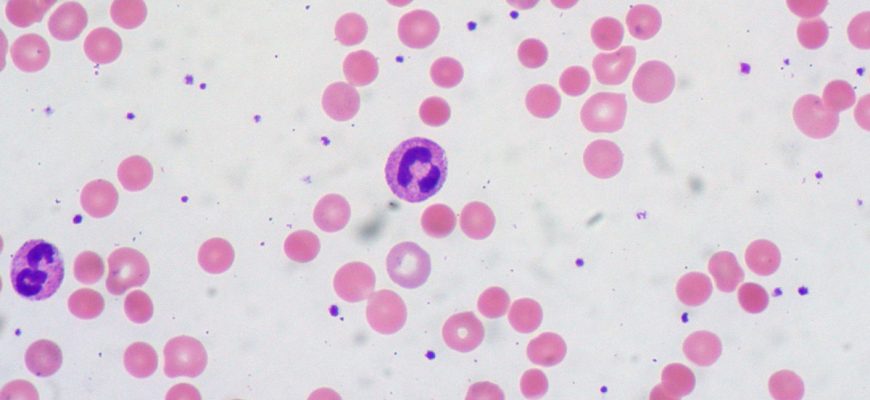

Виды Рака и Методы Раннего Выявления
Роль аутоантител: скрытые защитники или опасные враги? В современном мире науки о здоровье и медицине аутоантитела занимают особое место, вызывая как интерес
Роль аутоантител: Понимание и Значение в Современной Медицины Когда мы говорим о здоровье‚ мы часто фокусируемся на заболеваниях‚
Роль аутоантител: как они влияют на здоровье и что нужно знать каждому В современном мире все больше людей обращают внимание не только на внешнее здоровье
Роль аутоантител к опухолевым антигенам: раскрываем тайны иммунной системы в борьбе с раком В современном мире борьба с онкологическими заболеваниями остается
Роль аутоантител в нашем организме: мифы и реальность Когда речь заходит о здоровье и болезнях, одним из наиболее загадочных и сложных аспектов иммунологии
Роль аутоантител в нашем организме: враги и союзники иммунной системы Когда мы задумываемся о работе нашей иммунной системы, в основном представляем её
Роль аутоантител в диагностике: ключ к раскрытию тайн иммунной системы В современном мире медицина стремительно развивается, открывая все новые границы
Роль ctDNA: раскрываем тайны жидкой биопсии и возможности для diagnostics и терапии В последние годы область онкологии переживает революцию благодаря развитию
Роль ctDNA: как анализ циркулирующей опухолевой ДНК меняет подходы к диагностике и лечению рака В современном мире медицины постоянно происходят революционные
Роль ctDNA в современной медицине: открывая новые горизонты диагностики и лечения рака В последние годы научные достижения в области диагностики онкологических